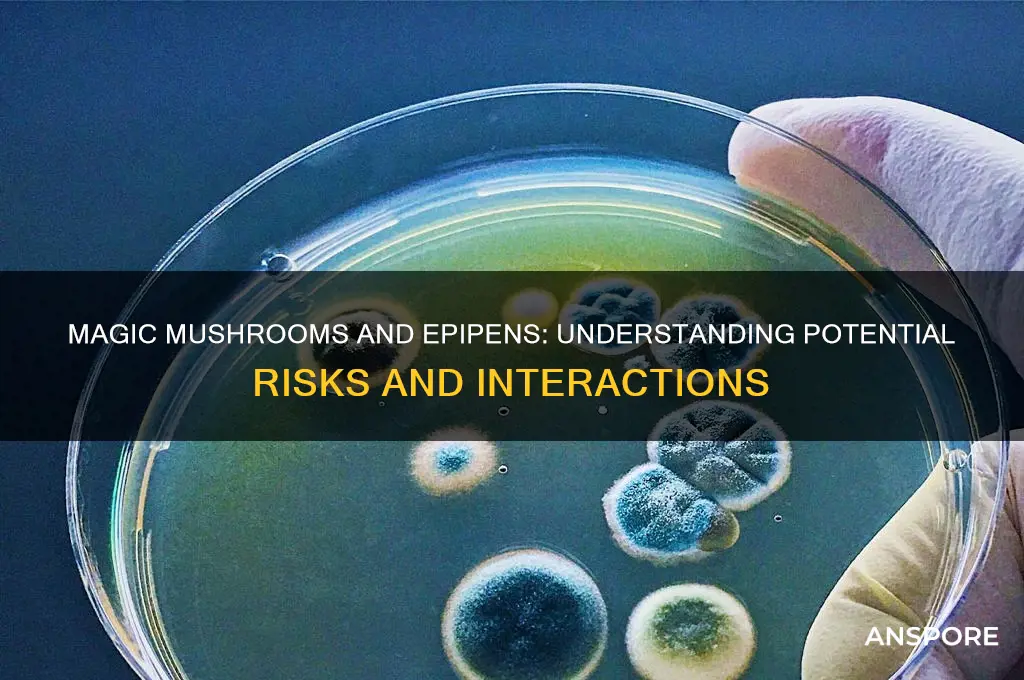
can i be given an epipen after taking magic mushrooms

Combining magic mushrooms with an EpiPen is a potentially dangerous mix that requires careful consideration. Magic mushrooms contain psilocybin, a psychoactive compound that can induce hallucinations and altered perceptions, while an EpiPen is a life-saving device used to treat severe allergic reactions, such as anaphylaxis. There is limited research on the direct interaction between psilocybin and epinephrine (the active ingredient in an EpiPen), but it is generally not recommended to use an EpiPen unless there is a clear medical need, as it can cause serious side effects like increased heart rate and elevated blood pressure. If you are experiencing a severe allergic reaction, it is crucial to seek immediate medical attention, regardless of any recent substance use. However, if you have taken magic mushrooms and are concerned about potential risks or interactions, consulting a healthcare professional is essential to ensure safe and appropriate care.
| Characteristics | Values |
|---|---|
| Interaction Between Epipen and Psilocybin | Limited research on direct interaction; no known contraindication but caution advised due to potential unpredictable effects. |
| Epipen Use | Epipen is used for anaphylaxis (severe allergic reactions); not indicated for mushroom-related symptoms unless anaphylaxis occurs. |
| Magic Mushrooms (Psilocybin) Effects | Hallucinations, altered perception, nausea, increased heart rate, anxiety, or panic. Rarely causes anaphylaxis unless allergic to fungi. |
| Medical Advice | Consult a healthcare professional immediately if severe symptoms occur after mushroom ingestion. Epipen use should only be considered if anaphylaxis is confirmed. |
| Risk of Overreaction | Using Epipen without anaphylaxis can cause harm (e.g., increased heart rate, hypertension). |
| Alternative Treatments | Symptomatic care for mushroom-related symptoms (e.g., benzodiazepines for anxiety, hydration for nausea). No specific antidote for psilocybin. |
| Precautionary Measures | Avoid mixing substances; ensure mushrooms are correctly identified to prevent poisoning. Have emergency contacts available. |
| Legal Considerations | Psilocybin is illegal in many regions; medical use is limited to research or decriminalized areas. Epipen use is regulated and requires a prescription. |
| Emergency Response | If anaphylaxis is suspected (e.g., difficulty breathing, swelling), administer Epipen and seek immediate medical attention. Otherwise, focus on managing mushroom-related symptoms. |
| Research Gaps | Lack of studies on Epipen and psilocybin interaction; reliance on clinical judgment in emergency situations. |
Explore related products
What You'll Learn
- Potential Allergic Reactions: Can magic mushrooms trigger allergies requiring an EpiPen
- Drug Interactions: Do mushrooms interact with epinephrine in the EpiPen
- Medical Risks: Are there risks in using an EpiPen after mushroom consumption
- Emergency Protocols: When should an EpiPen be administered post-mushroom use
- Professional Guidance: Should medical advice be sought before using an EpiPen in this scenario

Potential Allergic Reactions: Can magic mushrooms trigger allergies requiring an EpiPen?
Magic mushrooms, known for their psychoactive compound psilocybin, are generally considered safe for most users when consumed in controlled settings. However, like any substance, they can trigger adverse reactions, including potential allergic responses. While severe allergic reactions requiring an EpiPen are rare, they are not impossible. Reports of anaphylaxis from magic mushrooms are scarce but have been documented in medical literature, often linked to contaminants or individual sensitivities rather than psilocybin itself. If you experience symptoms like difficulty breathing, swelling, or hives after ingestion, seek immediate medical attention, as an EpiPen might be necessary in extreme cases.
Understanding the difference between an allergic reaction and other adverse effects is crucial. Common side effects of magic mushrooms, such as nausea, paranoia, or visual distortions, are not allergic responses and do not require an EpiPen. True allergies involve the immune system and can escalate rapidly. For instance, a case study published in the *Journal of Medical Toxicology* described a patient who developed anaphylaxis after consuming contaminated mushrooms, highlighting the importance of sourcing clean, properly identified species. If you suspect an allergy, consult an allergist before experimenting with psychedelics.
Prevention is key when it comes to avoiding allergic reactions. Start with a low dose (0.5–1 gram of dried mushrooms) to test tolerance, especially if you have a history of allergies or asthma. Avoid mixing mushrooms with other substances, as interactions can increase the risk of adverse effects. If you’re foraging wild mushrooms, ensure proper identification, as misidentification can lead to toxic or allergenic species. For those with known severe allergies, carrying an EpiPen is always a prudent precaution, regardless of the substance in question.
In the event of a suspected allergic reaction, act swiftly. Mild symptoms like itching or mild swelling may resolve with antihistamines, but severe symptoms like throat tightness or rapid heartbeat warrant emergency care. Medical professionals will assess the need for an EpiPen based on the severity of the reaction. Remember, while magic mushrooms are increasingly studied for therapeutic benefits, their safety profile is not universal, and individual responses can vary widely. Always prioritize caution and informed decision-making.
Can Quin Spot Teemo's Mushrooms? A League of Legends Insight
You may want to see also

Drug Interactions: Do mushrooms interact with epinephrine in the EpiPen?
Magic mushrooms, containing the psychoactive compound psilocybin, primarily affect serotonin receptors in the brain, inducing hallucinations and altered perceptions. Epinephrine, the active ingredient in an EpiPen, is a potent stimulant used to treat severe allergic reactions (anaphylaxis) by constricting blood vessels and relaxing airways. While these substances act on different physiological systems, their concurrent use raises questions about potential interactions. Psilocybin’s effects on heart rate and blood pressure, combined with epinephrine’s cardiovascular stimulation, could theoretically amplify stress on the heart. However, no clinical studies or case reports explicitly document interactions between psilocybin and epinephrine, leaving this concern largely theoretical.
In emergency situations, the priority is treating anaphylaxis, a life-threatening condition. Medical professionals are trained to administer epinephrine regardless of a patient’s recent drug use, as delaying treatment can be fatal. If a person experiencing anaphylaxis has recently consumed magic mushrooms, the benefits of epinephrine far outweigh potential risks. However, healthcare providers should be informed of recent psilocybin use to monitor for complications, such as elevated heart rate or hypertension, which may require additional interventions like beta-blockers or calcium channel blockers.
From a pharmacological perspective, psilocybin’s metabolism in the liver (via CYP enzymes) does not directly interfere with epinephrine’s mechanism of action. Epinephrine acts rapidly in the bloodstream, bypassing liver metabolism, and its effects are short-lived. While psilocybin’s psychological effects (anxiety, paranoia) could be exacerbated by epinephrine’s stimulant properties, this is more a concern of patient experience than a direct drug interaction. Practical advice for individuals includes carrying medical identification noting recent psilocybin use and informing emergency responders to ensure comprehensive care.
Comparatively, other substances like cocaine or amphetamines pose more significant risks when combined with epinephrine due to their direct cardiovascular effects. Psilocybin, while altering mental states, does not share this profile. Still, individuals should avoid self-medicating with magic mushrooms and seek professional guidance if considering their use, especially if they have a history of allergies or carry an EpiPen. In summary, while no evidence suggests a dangerous interaction between psilocybin and epinephrine, transparency with healthcare providers remains critical for safe and effective emergency treatment.
Mushrooms' Potential Role in Lowering ALT Levels: What Research Says
You may want to see also

Medical Risks: Are there risks in using an EpiPen after mushroom consumption?
Combining magic mushrooms with an EpiPen introduces a complex interplay of pharmacological effects that could exacerbate risks. Psilocybin, the active compound in mushrooms, primarily affects serotonin receptors, potentially causing elevated heart rate, blood pressure, and anxiety. An EpiPen, containing epinephrine, is designed to counteract severe allergic reactions by stimulating alpha and beta-adrenergic receptors, further increasing heart rate and blood pressure. When used together, these substances may create a synergistic cardiovascular strain, particularly dangerous for individuals with pre-existing heart conditions or hypertension. For instance, a 30-year-old with undiagnosed hypertension might experience a hypertensive crisis if an EpiPen is administered post-mushroom consumption.
From a procedural standpoint, the decision to administer an EpiPen should always prioritize the severity of the allergic reaction over the presence of psychedelics. Anaphylaxis is a life-threatening condition requiring immediate epinephrine, regardless of concurrent substances. However, medical providers must be aware of potential complications. Psilocybin’s psychological effects, such as paranoia or hallucinations, could complicate the patient’s response to treatment, making monitoring more challenging. In such cases, a lower dose of epinephrine (e.g., 0.15 mg for adults or 0.01 mg/kg for children) might be considered, though this should only be determined by a healthcare professional.
A comparative analysis of epinephrine and psilocybin reveals overlapping risks, particularly in cardiovascular and psychological domains. While epinephrine’s effects are short-lived (10–20 minutes), psilocybin’s can last 4–6 hours, prolonging the window of potential interaction. Studies on concurrent use are limited, but case reports suggest heightened anxiety and tachycardia in patients receiving epinephrine while under psychedelic influence. For example, a 25-year-old with a known peanut allergy experienced severe agitation and palpitations after EpiPen use during a mushroom trip, requiring benzodiazepines for symptom management.
Practically, individuals should avoid mixing substances to minimize risks. If an allergic reaction occurs after mushroom consumption, bystanders should call emergency services immediately and relay all ingested substances to responders. Carrying an EpiPen is non-negotiable for those with severe allergies, but they must inform their healthcare provider about recreational drug use to tailor emergency plans. For instance, a 40-year-old with a bee sting allergy might be advised to monitor vitals closely post-EpiPen use if mushrooms are in their system, using a blood pressure cuff and pulse oximeter at home.
In conclusion, while an EpiPen remains a critical intervention for anaphylaxis, its use after mushroom consumption demands caution. The combined cardiovascular and psychological effects could pose unique challenges, particularly in vulnerable populations. Healthcare providers and patients alike must balance the immediacy of allergic reactions with the potential for adverse interactions, ensuring informed decision-making in emergencies.
Exploring Michigan's Laws: Are Magic Mushrooms Legal to Purchase?
You may want to see also
Explore related products

Emergency Protocols: When should an EpiPen be administered post-mushroom use?
Immediate Action Required: Recognizing Anaphylaxis Post-Mushroom Ingestion
An EpiPen should only be administered if an individual exhibits clear signs of anaphylaxis after consuming magic mushrooms. Unlike typical psychedelic effects (e.g., visual distortions or anxiety), anaphylaxis presents as a rapid, severe allergic reaction. Symptoms include difficulty breathing, swelling of the throat or tongue, hives, rapid heartbeat, and a sharp drop in blood pressure. If these occur, act swiftly—delaying EpiPen use can be fatal. Note: Psychedelic reactions, though distressing, do not warrant EpiPen use unless allergic symptoms are confirmed.
Step-by-Step Protocol: Administering an EpiPen Safely
If anaphylaxis is suspected, follow these steps: 1) Call emergency services immediately. 2) Remove the EpiPen from its case and hold it firmly. 3) Inject the auto-injector into the middle of the outer thigh (through clothing if necessary). 4) Hold for 10 seconds, then massage the injection site for absorption. 5) Monitor the individual closely, as symptoms may re-emerge. A single EpiPen dose (0.3 mg epinephrine) is standard for adults and children over 30 lbs, but a second dose may be required if symptoms persist after 5–15 minutes. Always prioritize professional medical follow-up.
Cautions: Misuse Risks and Common Misconceptions
Using an EpiPen without confirmed anaphylaxis can cause harm, especially in individuals with heart conditions or hypertension. Epinephrine elevates heart rate and blood pressure, potentially triggering arrhythmias or stroke. Additionally, confusion arises from mistaking mushroom-induced panic or nausea for an allergic reaction. Key differentiator: Allergic reactions involve physical airway obstruction or skin manifestations, not solely psychological distress. Never administer an EpiPen based on assumption—verify symptoms first.
Comparative Analysis: Psychedelic Reactions vs. Allergic Emergencies
While magic mushrooms rarely cause true allergies, cross-contamination (e.g., mold or spores) may trigger reactions in sensitive individuals. Psychedelic effects—such as paranoia or gastrointestinal discomfort—mimic distress but lack the life-threatening markers of anaphylaxis. For instance, a 25-year-old experiencing mushroom-induced vomiting does not require an EpiPen unless accompanied by throat swelling or respiratory distress. Always cross-reference symptoms with anaphylaxis criteria before intervention.
Practical Tips: Preparedness and Prevention
If you or someone you know has a known allergy to fungi or mold, avoid mushroom use entirely. For first-time users, start with a low dose (0.5–1 gram dried mushrooms) in a controlled environment. Keep an EpiPen accessible only if a pre-existing allergy is confirmed. Educate companions on anaphylaxis recognition and EpiPen use. Lastly, document any adverse reactions post-mushroom use for future reference, even if an EpiPen was not needed. Proactive measures reduce risk and ensure informed decision-making.
Preserving Straw Mushrooms: A Beginner's Guide to Canning at Home
You may want to see also

Professional Guidance: Should medical advice be sought before using an EpiPen in this scenario?
Combining magic mushrooms with an EpiPen introduces a complex interplay of pharmacological effects and potential risks. Psilocybin, the active compound in magic mushrooms, primarily affects serotonin receptors in the brain, often leading to altered perception and mood. An EpiPen, on the other hand, delivers epinephrine, a potent stimulant used to treat severe allergic reactions (anaphylaxis). While there’s no direct contraindication between psilocybin and epinephrine, the physiological stress induced by both substances warrants caution. Epinephrine increases heart rate and blood pressure, which could exacerbate psilocybin-induced anxiety or cardiovascular strain. This raises the question: should professional medical advice be sought before administering an EpiPen in this scenario?
From an analytical perspective, the decision hinges on the severity of the allergic reaction versus the potential risks of combining these substances. If anaphylaxis is suspected—characterized by symptoms like throat swelling, difficulty breathing, or a sudden drop in blood pressure—immediate EpiPen use is non-negotiable. Delaying treatment could be life-threatening. However, if the reaction is mild (e.g., hives or itching), consulting a healthcare provider first is advisable. They can weigh the risks of epinephrine administration in the context of psilocybin use, considering factors like dosage (typical psilocybin doses range from 1–5 grams) and individual health history.
Instructively, if you’re in a situation where an EpiPen is needed after consuming magic mushrooms, follow these steps: first, assess the severity of the allergic reaction. If it’s severe, administer the EpiPen immediately, as the risk of anaphylaxis outweighs concerns about psilocybin interaction. Second, call emergency services promptly, as epinephrine’s effects are temporary, and further medical intervention may be required. Third, inform responders about both the allergic reaction and psilocybin use to ensure appropriate care. For mild reactions, contact a poison control center or healthcare provider for guidance before using the EpiPen.
Persuasively, seeking professional advice in this scenario is not just prudent—it’s essential. Psilocybin’s effects on perception and cognition can complicate self-assessment of an allergic reaction. For instance, a person under its influence might misinterpret symptoms or delay action. Additionally, healthcare providers can offer tailored advice, such as monitoring for signs of serotonin syndrome (a rare but serious condition caused by excessive serotonin activity) or adjusting EpiPen dosage for children or elderly individuals. Proactive consultation minimizes risks and ensures informed decision-making.
Comparatively, consider the approach to other drug interactions. Just as one wouldn’t self-medicate with an EpiPen while on stimulants like cocaine or ADHD medications without medical input, the same caution applies here. Psilocybin’s serotonergic effects and epinephrine’s adrenergic effects could theoretically interact in unpredictable ways, particularly in individuals with pre-existing conditions like hypertension or heart disease. While data on this specific interaction is limited, the precautionary principle—prioritizing safety in the absence of definitive evidence—strongly supports consulting a professional.
In conclusion, while an EpiPen should never be withheld in a severe allergic reaction, the context of psilocybin use adds layers of complexity. For mild reactions, professional guidance is critical to balancing risks and benefits. Practical tips include keeping emergency contacts readily available and informing companions about your psilocybin use and allergy history. Ultimately, the decision to use an EpiPen in this scenario should be informed by expert advice, ensuring both immediate safety and long-term well-being.
Mushrooms for Babies: Safe for 10-Month-Olds to Eat?
You may want to see also
Frequently asked questions
EpiPens are used to treat severe allergic reactions (anaphylaxis), not the effects of magic mushrooms. If you’re experiencing a bad trip or adverse reaction, seek medical help, but an EpiPen is not the appropriate treatment.
No, an EpiPen contains epinephrine, which is designed to treat allergic reactions, not the psychoactive effects of psilocybin found in magic mushrooms.
If you suspect an allergic reaction (e.g., difficulty breathing, swelling, hives), an EpiPen may be appropriate if you have a known allergy and a prescribed EpiPen. Otherwise, seek immediate medical attention.
There’s no evidence that magic mushrooms interfere with the effectiveness of an EpiPen. However, the effects of psilocybin may complicate symptoms, so medical evaluation is crucial.
If you’re experiencing distress from magic mushrooms, stay calm, seek a safe environment, and contact medical professionals for guidance. An EpiPen is not a solution for mushroom-related issues.

























